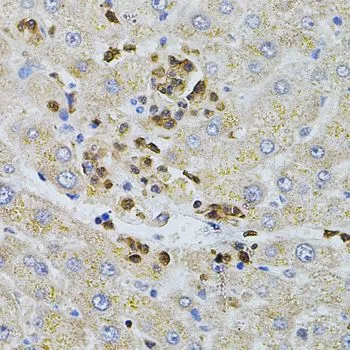

IHC-P analysis of rat brain tissue using GTX64583 Bestrophin 1 antibody. Dilution : 1:100
Bestrophin 1 antibody
GTX64583
ApplicationsWestern Blot, ImmunoHistoChemistry, ImmunoHistoChemistry Paraffin
Product group Antibodies
ReactivityHuman, Mouse, Rat
TargetBEST1
Overview
- SupplierGeneTex
- Product NameBestrophin 1 antibody
- Delivery Days Customer9
- Application Supplier NoteWB: 1:500 - 1:2000. IHC-P: 1:50 - 1:200. *Optimal dilutions/concentrations should be determined by the researcher.Not tested in other applications.
- ApplicationsWestern Blot, ImmunoHistoChemistry, ImmunoHistoChemistry Paraffin
- CertificationResearch Use Only
- ClonalityPolyclonal
- ConjugateUnconjugated
- Gene ID7439
- Target nameBEST1
- Target descriptionbestrophin 1
- Target synonymsARB, BEST, BMD, Best1V1Delta2, RP50, TU15B, VMD2, bestrophin-1, Best disease, vitelliform macular dystrophy protein 2
- HostRabbit
- IsotypeIgG
- Protein IDO76090
- Protein NameBestrophin-1
- Scientific DescriptionThis gene encodes a member of the bestrophin gene family. This small gene family is characterized by proteins with a highly conserved N-terminus with four to six transmembrane domains. Bestrophins may form chloride ion channels or may regulate voltage-gated L-type calcium-ion channels. Bestrophins are generally believed to form calcium-activated chloride-ion channels in epithelial cells but they have also been shown to be highly permeable to bicarbonate ion transport in retinal tissue. Mutations in this gene are responsible for juvenile-onset vitelliform macular dystrophy (VMD2), also known as Best macular dystrophy, in addition to adult-onset vitelliform macular dystrophy (AVMD) and other retinopathies. Alternative splicing results in multiple variants encoding distinct isoforms.[provided by RefSeq, Nov 2008]
- ReactivityHuman, Mouse, Rat
- Storage Instruction-20°C or -80°C,2°C to 8°C
- UNSPSC12352203

![WB analysis of human RPE cell lysate using GTX30219 Bestrophin antibody[E6-6].](https://www.genetex.com/upload/website/prouct_img/normal/GTX30219/GTX30219_1367_WB_w_23060722_540.webp)
